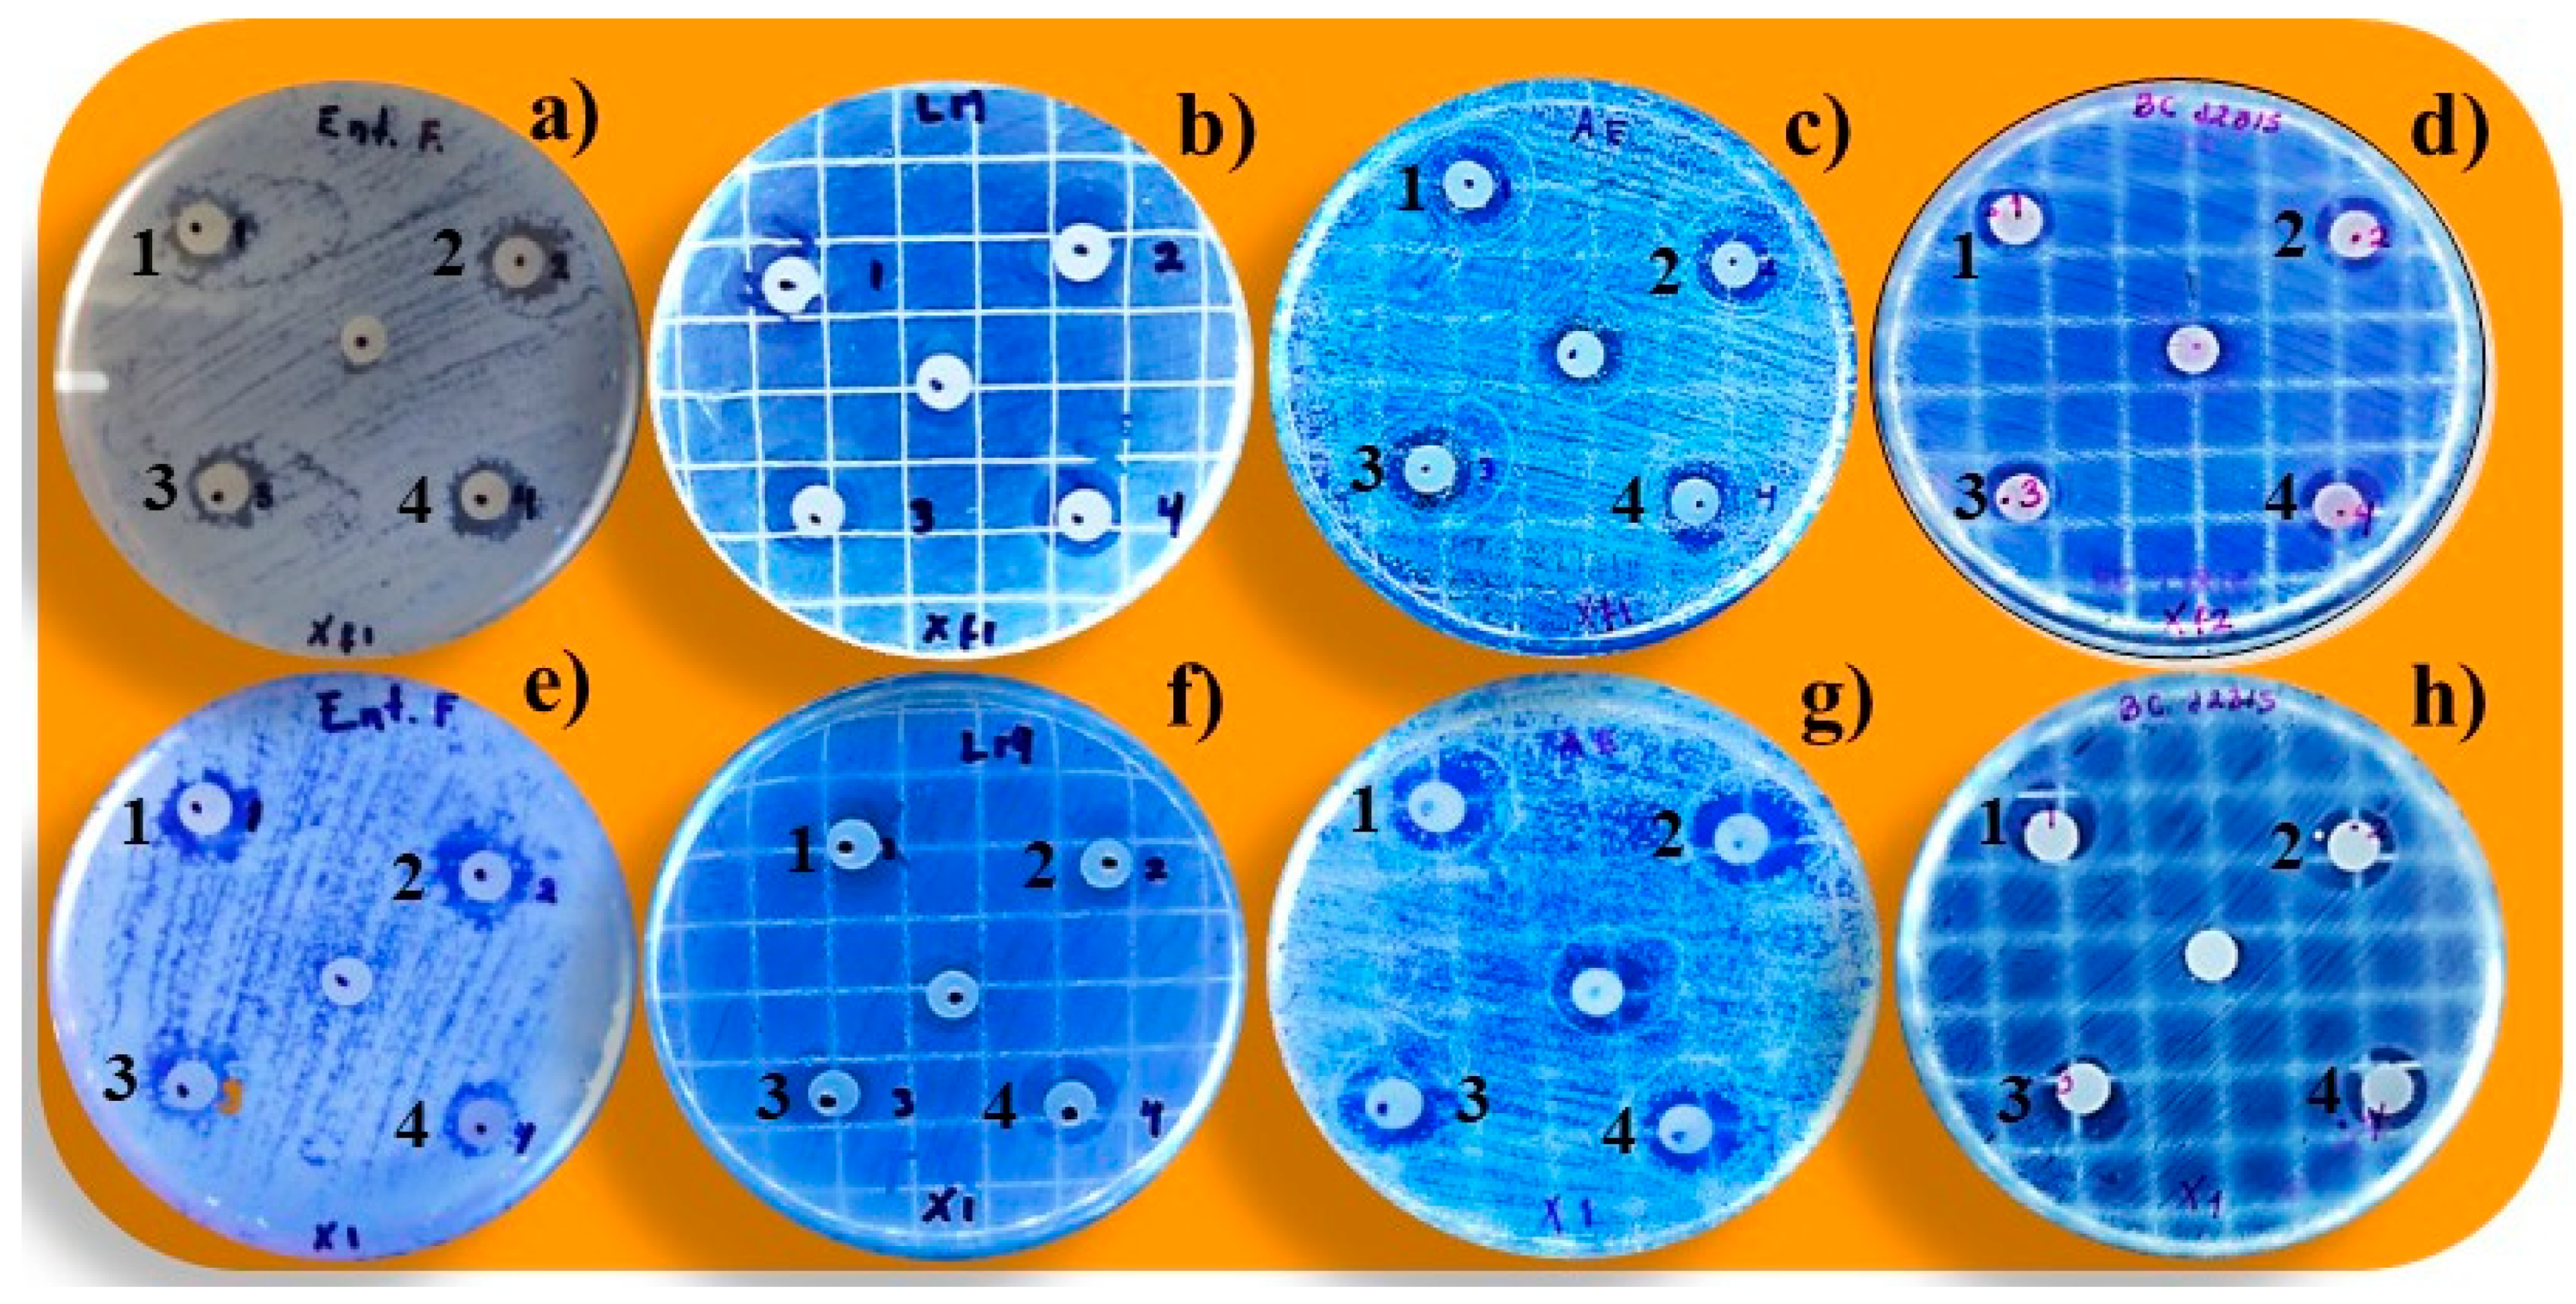
Applsci 13 00558 g001 Applsci 13 00558 g001

Antibacterial Activity of Crude Extract and Purified Acetogenins from Annona muricata Seeds
Abstract
1. Introduction
2. Materials and Methods
2.1. Reagents
2.2. Bacterial Strains
2.3. Obtaining Crude Extract and Purified Acetogenins
2.4. Antibacterial Assays of Crude Extract and Purified Acetogenins
2.5. Minimum Inhibitory Concentration (MIC) of the Crude Extract and Purified Acetogenins against Gram-Positive and Gram-Segative Bacteria
2.6. Inhibition Percentage of the Most Prevalent Harmful Bacteria Found in Foods: Enterococcus faecalis, Salmonella paratyphi, Escherichia coli, and Listeria monocytogenes by the Crude Extract and Purified Acetogenins
2.7. Measurement of the Membrane Potential of Enterococcus faecalis, Listeria monocytogenes, Salmonella paratyphi, and Escherichia coli Treated with the Crude Extract and Purified Acetogenins
2.8. Lethality and Sublethal Injury on Enterococcus faecalis, Listeria monocytogenes, and Escherichia coli Caused by the Crude Extract and Purified Acetogenins
2.9. Statistical Analysis
3. Results and Discussion
3.1. Antibacterial Assays of Crude Extract and Purified Acetogenins
3.2. Minimum Inhibitory Concentration (MIC) of the Crude Extract and Purified Acetogenins against Gram-Positive and Gram-Negative Bacteria
3.3. Inhibition Percentage of the Most Prevalent Harmful Bacteria Found in Foods: Enterococcus faecalis, Salmonella paratyphi, Escherichia coli, and Listeria monocytogenes by the Crude Extract and Purified Acetogenins
3.4. Measurement of the Membrane Potential of E. faecalis, Listeria monocytogenes, Salmonella paratyphi, and Escherichia coli Treated with the Crude Extract and Purified Acetogenins
3.5. Lethality and Sublethal Injury on Enterococcus faecalis, Listeria monocytogenes, and Escherichia coli Caused by the Crude Extract and Purified Acetogenins
4. Conclusions
Author Contributions
Funding
Institutional Review Board Statement
Informed Consent Statement
Data Availability Statement
Acknowledgments
Conflicts of Interest
References
- Aguilar-Hernández, G.; Zepeda-Vallejo, L.G.; García-Magaña, M.L.; López-García, U.M.; Aguilera-Aguirre, S.; Montalvo-González, E. Acetogenin content from soursop fruit (Annona muricata L.) seeds: Evaluation of different extraction conditions. Biotecnia 2022, 24, 12–19. [Google Scholar] [CrossRef]
- Pinto, A.C.Q.; Cordeiro, M.C.R.; de Andrade, F.R.; Ferreira, H.A.; de Filgueiras, C.; Alves, D.E.; Kinpara, D.I. Annona Species; International Centre for Underutilized Crops, University of Southampton: Southampton, UK, 2005; pp. 1–284. [Google Scholar]
- Aguilar-Hernández, G.; García-Magaña, M.L.; Vivar-Vera, M.A.; Sáyago-Ayerdi, S.G.; Sánchez-Burgos, J.A.; Morales-Castro, J.; Montalvo-González, E. Optimization of ultrasound-assisted extraction of phenolic compounds from Annona muricata by-products and pulp. Molecules 2019, 24, 904. [Google Scholar] [CrossRef] [PubMed]
- Duran-Ruíz, C.A.; Cruz-Ortega, R.; Zaldívar-Riverón, A.; Zavaleta-Mancera, H.A.; de la Cruz-Chacón, I.; González-Esquinca, A.R. Ontogenic synchronization of Bephratelloides cubensis, Annona macroprophyllata seeds and acetogenins from Annonaceae. J. Med. Plant Res. 2019, 132, 81–91. [Google Scholar] [CrossRef] [PubMed]
- Aguilar-Hernández, G.; Vivar-Vera, M.A.; García-Magaña, M.L.; González-Silva, N.; Pérez-Larios, A.; Montalvo-González, E. Ultrasound-assisted extraction of total acetogenins from the soursop fruit by response surface methodology. Molecules 2020, 25, 1139. [Google Scholar] [CrossRef] [PubMed]
- Hernández-Fuentes, L.M.; Montalvo-González, E.; García-Magaña, M.L.; Anaya-Esparza, L.M.; Nolasco-González, Y.; Villagrán, Z.; González-Torres, S.; Velázquez-Monreal, J.J.; Morelos-Flores, D.A. Current situation and perspectives of fruit Annonaceae in Mexico: Biological and agronomic importance and bioactive properties. Plants 2022, 11, 7. [Google Scholar] [CrossRef]
- Abe, M.; Murai, M.; Ichimaru, N.; Kenmochi, A.; Yoshida, T.; Kubo, A.; Miyoshi, H. Dynamic function of the alkyl spacer of acetogenins in their inhibitory action with mitochondrial complex I (NADH-ubiquinone oxidoreductase). Biochemistry 2005, 44, 14898–14906. [Google Scholar] [CrossRef]
- Bermejo, A.; Figadére, B.; Zafra-Polo, M.C.; Barrachina, I.; Estornell, E.; Cortes, D. Acetogenins from Annonaceae: Recent progress in isolation, synthesis and mechanisms of action. Nat. Prod. Res. 2005, 22, 269–303. [Google Scholar] [CrossRef]
- Coria-Téllez, A.V.; Montalvo-González, E.; Yahia, E.M.; Obledo-Vázquez, E.N. Annona muricata: A comprehensive review on its traditional medicinal uses, phytochemicals, pharmacological activities, mechanisms of action and toxicity. Arab. J. Chem 2016, 11, 662–691. [Google Scholar] [CrossRef]
- Agu, K.C.; Okolie, N.P.; Falodun, A.; Engel-Lutz, N. In vitro anticancer assessments of Annona muricata fractions and in vitro antioxidant profile of fractions and isolated acetogenin (15-acetyl guanacone). J. Cancer Res. Pract. 2018, 5, 53–66. [Google Scholar] [CrossRef]
- León-Fernández, A.E.; Martínez, L.; Zepeda-Vallejo, L.G.; Arteaga-Garibay, R.I.; Gutiérrez-Martínez, P.; Montalvo-González, E. Antibacterial, antifungal, antioxidant and toxic effect of fractioned extracts from Soursop pulp. Bio Ciencias 2019, 6, e400. [Google Scholar] [CrossRef]
- Terezan, A.P.; Joáo, G.M.; Junqueira, V.G.; Wakui, L.K.; Oliveira, A.; Martins, C.E.; Santiago, M.B.; Severino, V.P. Qualitative analysis of acetogenins from Annona coriaceae leaves (Annonaceae) by HPLC-Q-Orbitrap and their antibacterial potential against oral pathogens. Nat. Prod. Res. 2020, 36, 765–771. [Google Scholar] [CrossRef] [PubMed]
- Aguilar-Villalva, R.; Molina, G.A.; España-Sánchez, B.L.; Díaz-Peña, L.F.; Elizalde-Mata, A.; Valerio, E.; Estevez, M. Antioxidant capacity and antibacterial activity from Annona cherimola phytochemicals by ultrasound-assisted extraction and its comparison to conventional methods. Arab. J. Chem. 2021, 14, 103239. [Google Scholar] [CrossRef]
- Indrianingsih, A.W.; Wulanjati, M.P.; Windarsih, A.; Bhattacharjya, D.K.; Suzuki, T.; Katayama, T. In vitro studies of antioxidant, antidiabetic, and antibacterial activities of Theobroma cacao, Anonna muricata and Clitoria ternatea. Biocatal. Agric. Biotechnol. 2021, 33, 101995. [Google Scholar] [CrossRef]
- Falagas, M.E.; Kyriakidou, M.; Voulgaris, G.L.; Vokos, F.; Politi, S.; Kechagias, K.S. Clinical use of intravenous polymyxin B for the treatment of patients with multidrug-resistant Gram-negative bacterial infections: An evaluation of the current evidence. J. Glob. Antimicrob. Resist. 2021, 24, 342–359. [Google Scholar] [CrossRef] [PubMed]
- Pinto, N.C.C.; Campos, L.M.; Evangelista, A.C.S.; Lemos, A.S.O.; Silva, T.P.; Melo, R.C.N.; Fabri, R.L. Antimicrobial Annona muricata L. (soursop) extract targets the cell membranes of Gram-positive and Gram-negative bacteria. Ind. Crops Prod. 2017, 107, 332–340. [Google Scholar] [CrossRef]
- Zafra-Polo, M.C.; González, M.C.; Estornell, E.; Sahpaz, S.; Cortes, D. Acetogenins from annonaceae, inhibitors of mitochondrial complex I. Phytochemistry 1996, 42, 253–271. [Google Scholar] [CrossRef]
- Raybaudi-Massilia, R.; Suárez, A.I.; Arvelo, F.; Sojo, F.; Mosqueda-Melgar, J.; Zambrano, A.; Calderón-Gabaldón, M.I. An analysis in vitro of the cytotoxic, antioxidant and antimicrobial activity of aqueous and alcoholic extracts of Annona muricata L. seed and pulp. Br. J. Appl. Sci. Technol. 2015, 5, 333. [Google Scholar] [CrossRef]
- Neglo, D.; Tettey, C.O.; Essuman, E.K.; Amenu, J.D.; Mills-Robertson, F.C.; Sedohia, D.; Adjoa, A.B.; Abaye, D.A. Evaluation of the modulatory effect of Annona muricata extracts on the activity of some selected antibiotics against biofilm-forming MRSA. Evid. Based Complement. Altern. Med. 2021, 2021, 9342110. [Google Scholar] [CrossRef]
- Hoe, P.K.; Yiu, P.H.; Ee, G.C.L.; Wong, S.C.; Rajan, A.; Bong, C.F. Biological activity of Annona muricata seed extracts. Malays. J. Sci. 2010, 29, 153–159. [Google Scholar] [CrossRef]
- López-Romero, B.A.; Luna-Bárcenas, G.; García-Magaña, M.L.; Anaya-Esparza, L.M.; Zepeda-Vallejo, L.G.; López-García, U.M.; Ortiz-Basurto, R.I.; Aguilar-Hernández, G.; Pérez-Larios, A.; Montalvo-González, E. Extraction of Acetogenins Using Thermosonication-Assisted Extraction from Annona muricata Seeds and Their Antifungal Activity. Molecules 2022, 27, 6045. [Google Scholar] [CrossRef]
- Yang, H.J.; Li, X.; Zhang, N.; Chen, J.W.; Wang, M.Y. Two new cytotoxic acetogenins from Annona squamosa. J. Asian Nat. Prod. Res. 2009, 11, 250–256. [Google Scholar] [CrossRef] [PubMed]
- Anaya-Esparza, L.M.; Montalvo-González, E.; González-Silva, N.; Méndez-Robles, M.; Romero-Toledo, R.; Yahia, E.; Pérez-Larios, A. Synthesis and characterization of TiO2-ZnO-MgO mixed oxide and their antibacterial activity. Materials 2019, 12, 698. [Google Scholar] [CrossRef]
- Parhusip, A.J.N.; Sitanggang, A.B. Antimicrobial activity of melinjo (Gnetum gnemon) seed and peel extract against selected pathogenic bacteria. Microbiol. Indones. 2011, 5, 103–112. [Google Scholar] [CrossRef]
- Bibi, Y.; Nisa, S.; Chaudhary, F.M.; Zia, M. Antibacterial activity of some selected medicinal plants from Pakistan. BMC Complement. Altern. Med. 2011, 11, 52. [Google Scholar] [CrossRef] [PubMed]
- Khater, M.; Khater, S.S.; Gholap, H.; Patil, R.; Kulkarni, G. Comparative studies on measurement of membrane potential of bacterial cells treated with ZnO nanoparticles by Spectrofluorometry, fluorescence microscopy and flowcytometry. J. Microbiol. Methods 2020, 173, 105920. [Google Scholar] [CrossRef] [PubMed]
- Anaya-Esparza, L.M.; González-Silva, N.; Yahia, E.M.; González-Vargas, O.A.; Montalvo-González, E.; Pérez-Larios, A. Effect of TiO2-ZnO-MgO mixed oxide on microbial growth and toxicity against Artemia salina. Nanomaterials 2019, 9, 992. [Google Scholar] [CrossRef]
- Trindade, M.L.; Martins, D.A.; Radünz, M.; Ramos, A.; Silveira, C.; Silva, G.; Avila, E.; Helbig, E. Chemical characterization, antimicrobial and antioxidant activity of Annona (Annona squamosa L.) pulp extract. Chil. J. Nutr. 2022, 47, 281–285. [Google Scholar] [CrossRef]
- Rodriguez-Pérez, J.L.; Millones-Gómez, P.A. Antibacterial effect of Annona muricata L. leaves on Streptococcus mutans ATCC 25175 strains. J. Clin. Diagn. Res. 2019, 13, 1–16. [Google Scholar] [CrossRef]
- Masato, A.; Kubo, A.; Yamamoto, S.; Hatoh, Y.; Murai, M.; Hattori, Y. Dynamic function of the spacer region of acetogenins in the inhibition of bovine mitocondrial NADH-ubiquinone oxidoreductase (complex I). Biochemistry 2008, 47, 6260–6266. [Google Scholar] [CrossRef]
- Rowlett, V.W.; Mallampalli, V.K.P.S.; Karlstaedt, A.; Dowhan, W.; Taegtmeyer, H.; Margolin, W.; Vitrac, H. Impact of membrane phospholipid alterations in Escherichia coli on cellular function and bacterial stress adaptation. J. Bacteriol. 2017, 199, 1–50. [Google Scholar] [CrossRef]
- Campos, L.M.; Lemos, A.S.O.; Silva, T.P.; Melo, R.M.N.; Apolônio, A.C.M.; Fabri, R.L. Antibacterial activity of ethanolic extract from Annona squamosa leaves against Gram-positive and Gram-negative bacteria. Glob. J. Pathol. Microbiol. 2021, 9, 1–9. [Google Scholar] [CrossRef]
- Ríos, J.L.; Recio, M.C. Medicinal plants and antimicrobial activity. J. Ethnopharmacol. 2005, 100, 80–84. [Google Scholar] [CrossRef] [PubMed]
- Obum-Nnadi, C.N.; Ezenwa, C.M.; Amaechi, D.; Ohabughiro, N.B.; Nnagbo, P.A.; Nwokorie, K.S.; Okoli, C.S. Evaluation of the Antimicrobial and Phytochemical Properties of Annona muricata L. (Soursop). J. Biomed. Biosens. 2022, 2, 43–59. Available online: https://www.gpub.org/ (accessed on 29 October 2022).
- Da Silva, B.D.; Patricia Bernardes, P.; Pinheiro, P.F.; Giorgio, J.D.; Domenici, G.C. Plectranthus amboinicus (Lour.) Spreng. essential oil as a natural alternative for the conservation of beef patties stored under refrigeration. Food Biosci. 2022, 49, 101896. [Google Scholar] [CrossRef]
- Siderakou, D.; Zilelidou, E.; Poimenidou, S.; Tsipra, I.; Ouranou, E.; Papadimitriou, K.; Skandamis, P. Assessing the survival and sublethal injury kinetics of Listeria monocytogenes under different food processing-related stresses. Int. J. Food Microbiol. 2021, 346, 109–159. [Google Scholar] [CrossRef] [PubMed]
- Salinas-Salazar, C.; Hernández-Brenes, C.; Rodríguez-Sánchez, D.G.; Castillo, E.C.; Navarro-Silva, J.M.; Pacheco, A. Inhibitory activity of avocado seed fatty acid derivatives (acetogenins) against Listeria monocytogenes. J. Food Sci. 2016, 82, 134–144. [Google Scholar] [CrossRef]
- Vairappan, C.S.; Tan, K.L. C15 halogenated acetogenin with antibacterial activity against food pathogens. Malays. J. Sci. 2009, 28, 263–268. [Google Scholar] [CrossRef]
- Oyedeji, O.; Taiwo, F.O.; Ajayi, O.S.; Ayinde, F.; Oziegbe, M.; Oseghare, C.O. Biocidal and Phytochemical analysis of leaf extracts of Annona muricata (Linn.). Int. J. Sci. Basic Appl. Res. 2015, 24, 76–87. [Google Scholar]
- Rottenberg, H.; Wu, S. Quantitative assay by flow cytometry of the mitochondrial membrane potential in intact cells. Biochim. Biophys. Acta Mol. Cell Res. 1998, 1404, 393–404. [Google Scholar] [CrossRef]
- Sánchez-Torres, L.E.; Espinosa-Bonilla, A.; Diosdado-Vargas, F. Flow cytometry, a universe of possibilities in the veterinary field. Review. J. Livest. Sci. 2022, 13, 763–786. [Google Scholar]
- Gutiérrez-del-Río, I.; Fernández, J.; Lombó, F. Plant nutraceuticals as antimicrobial agents in food preservation: Terpenoids, polyphenols and thiols. Int. J. Antimicrob. Agents 2018, 52, 309–315. [Google Scholar] [CrossRef] [PubMed]
- Kethireddy, V.; Oey, I.; Jowett, T.; Bremer, P. Critical analysis of the maximum non-inhibitory concentration (MNIC) method for quantifying sublethal lesions in Saccharomyces cerevisiae cells exposed to heat or pulsed electric field treatments. Int. J. Food Microbiol. 2016, 233, 73–80. [Google Scholar] [CrossRef] [PubMed]
- Villarreal-Lara, R.; Rodríguez-Sánchez, D.G.; Díaz De La Garza, R.I.; García-Cruz, M.I.; Castillo, A.; Pacheco, A.; Hernández-Brenes, C. Purified avocado seed acetogenins: Antimicrobial spectrum and complete inhibition of Listeria monocytogenes in a refrigerated food matrix. CyTA J. Food 2019, 17, 228–239. [Google Scholar] [CrossRef]

| Concentration (µg/mL) | Inhibition Halo (mm) Bacteria Gram-Positive | |||||
|---|---|---|---|---|---|---|
| Streptococcus mitis | Listeria monocytogenes | Staphylococcus aureus | ||||
| CE | P-ACGs | CE | P-ACGs | CE | P-ACGs | |
| 4000 | 8.00 ± 0.01 aY | 14.00 ± 1.15 aX | 16.00 ± 1.00 aX | 14.33 ± 0.58 bcY | 14.25 ± 0.50 aX | 15.75 ± 0.96 aX |
| 2000 | 8.00 ± 0.01 aY | 12.50 ± 0.58 abX | 11.33 ± 0.58 dY | 16.00 ± 1.00 abX | 14.50 ± 0.58 aX | 16.00 ± 0.82 aX |
| 1000 | 8.00 ± 0.01 aY | 12.00 ± 0.01 bX | 14.00 ± 1.00 bcX | 13.00 ± 1.00 cdX | 15.00 ± 0.01 aX | 15.00 ± 0.01 aX |
| 800 | 8.00 ± 0.01 aY | 12.00 ± 0.01 bX | 15.00 ± 1.00 abY | 18.00 ± 0.01 aX | NI | 15.50 ± 0.58 aX |
| 400 | 8.00 ± 0.01 aY | 12.00 ± 0.01 bX | 15.00 ± 1.00 abY | 17.00 ± 1.00 aX | NI | NI |
| 200 | 8.00 ± 0.01 aY | 12.00 ± 0.01 bX | 12.67 ± 0.29 cdY | 14.33 ± 0.58 bcX | NI | NI |
| 100 | 8.00 ± 0.01 aY | 11.00 ± 0.01 cX | 12.50 ± 0.50 cdX | 13.00 ± 0.01 dX | NI | NI |
| 50 | 8.00 ± 0.01 aY | 10.50 ± 0.58 cX | 12.00 ± 0.01 dX | 12.05 ± 0.50 dX | NI | NI |
| 25 | 8.00 ± 0.01 aY | 10.50 ± 0.58 cX | 12.00 ± 0.01 dX | 12.00 ± 0.01 dX | NI | NI |
| 12.5 | 8.00 ± 0.01 aY | 10.00 ± 1.15 cX | 12.00 ± 0.01 dX | 12.00 ± 0.01 dX | NI | NI |
| Ampicillin (500 μg/mL) | 23.00 ± 0.82 * | 15.00 ± 1.00 * | 16.25 ± 0.50 * | |||
| Distilled water | NI | NI | NI | |||
| Dimethyl sulfoxide | NI | NI | NI | |||
| Concentration (µg/mL) | Inhibition Halo (mm) Bacteria Gram-Positive | |||||
| Enterococcus faecalis | Streptococcus mutans | Streptococcus salivaris | ||||
| CE | P-ACGs | CE | P-ACGs | CE | P-ACGs | |
| 4000 | 14.00± 0.01 bY | 15.33 ± 0.58 aX | NI | 14.33 ± 0.58 aX | 7.00 ± 0.01 aY | 8.00 ± 0.01 aX |
| 2000 | 15.00 ± 0.01 aX | 15.67 ± 0.58 aX | NI | 12.67 ± 1.15 abX | 7.00 ± 0.01 aY | 8.00 ± 0.01 aX |
| 1000 | 14.67 ± 0.58 abX | 14.33 ± 0.58 bX | NI | 12.00 ± 1.73 abX | 7.00 ± 0.01 aX | 7.00 ± 0.01 bX |
| 800 | 13.00 ± 0.02 cY | 14.33 ± 0.58 bX | NI | 11.67 ± 0.58 abX | 7.00 ± 0.01 aX | 7.00 ± 0.01 bX |
| 400 | 14.00 ± 0.02 bX | 14.00 ± 0.02 bX | NI | 12.67 ± 0.58 abX | 7.00 ± 0.01 aX | 7.00 ± 0.01 bX |
| 200 | 12.33 ± 0.58 cX | 13.00 ± 0.02 cX | NI | 12.67 ± 1.53 abX | 7.00 ± 0.01 aX | 7.00 ± 0.01 bX |
| 100 | 11.33 ± 0.58 dX | 12.00 ± 0.02 dX | NI | 11.00 ± 0.02 abX | 7.00 ± 0.01 aX | 7.00 ± 0.01 bX |
| 50 | 10.33 ± 0.58 eX | 11.00 ± 0.01 eX | NI | 10.33 ± 1.15 abX | 7.00 ± 0.01 aX | 7.00 ± 0.01 bX |
| 25 | 10.33 ± 0.58 eX | 11.00 ± 0.02 eX | NI | 9.00 ± 0.01 cdX | 7.00 ± 0.01 aX | 7.00 ± 0.01 bX |
| 12.5 | 9.33 ± 0.58 fY | 11.00 ± 0.02 eX | NI | 8.00 ± 0.01 dX | 7.00 ± 0.01 aX | 7.00 ± 0.01 bX |
| Ampicillin (500 μg/mL) | 27.33 ± 0.58 * | 48.33 ± 0.58 * | 33.50 ± 0.58 * | |||
| Distilled water | NI | NI | NI | |||
| Dimethyl sulfoxide | NI | NI | NI | |||
| Concentration (µg/mL) | Inhibition Halo (mm) Bacteria Gram-Negative | |||||
|---|---|---|---|---|---|---|
| Aeromonas hydrophila | Escherichia coli | Salmonella cholerasius | ||||
| CE | P-ACGs | CE | P-ACGs | CE | P-ACGs | |
| 4000 | 12.00 ± 0.01 aX | 11.00 ± 0.01 abY | 9.33 ± 0.58 bX | 9.33 ± 0.58 bX | 9.67 ± 0.58 abcdY | 11.33 ± 1.15 abX |
| 2000 | 11.00 ± 0.01 aX | 11.00 ± 0.01 abX | 9.33 ± 0.58 bX | 9.33 ± 0.58 bX | 10.67 ± 0.58 aX | 11.33 ± 0.58 abX |
| 1000 | 11.67 ± 0.58 aX | 11.67 ± 0.58 aX | 9.33 ± 0.58 bX | 9.33 ± 0.58 bX | 9.33 ± 0.58 bcdY | 11.00 ± 0.01 bX |
| 800 | 12.33 ± 0.58 aX | 11.33 ± 0.58 aX | 10.67 ± 0.58 aX | 10.67 ± 0.58 aX | 10.33 ± 0.58 abX | 11.00 ± 0.02 bX |
| 400 | 11.67 ± 1.15 aX | 11.00 ± 0.01 abX | 10.67 ± 0.58 aX | 10.67 ± 0.58 aX | 10.00 ± 0.01 abcY | 12.67 ± 0.58 aX |
| 200 | 12.00 ± 0.01 aX | 11.00 ± 1.00 abX | 9.33 ± 0.58 bX | 10.33 ± 0.58 aX | 9.00 ± 0.02 cdY | 10.67 ± 1.15 bcX |
| 100 | 11.67 ± 1.15 aX | 10.33 ± 0.58 bX | 9.00 ± 0.02 bY | 10.33 ± 0.58 aX | 9.33 ± 1.15 bcdX | 10.67 ± 1.15 bcX |
| 50 | 11.33 ± 0.58 aX | 10.33 ± 0.58 bX | 9.00 ± 0.02 bY | 10.00 ± 0.02 abX | 8.67 ± 1.15 dY | 10.00 ± 0.01 bcX |
| 25 | 11.67 ± 1.15 aX | 10.33 ± 0.58 bX | 9.00 ± 0.01 bY | 10.00 ± 0.01 abX | 8.67 ± 1.15 dY | 10.33 ± 1.15 bcX |
| 12.5 | 12.33 ± 0.58 aY | 10.33 ± 0.58 bX | 9.00 ± 0.01 bY | 10.00 ± 0.02 abX | 9.33 ± 0.58 bcdX | 9.33 ± 0.58 cX |
| Ampicillin (500 μg/mL) | NI | 28.66 ± 0.58 * | NI | |||
| Distilled water | NI | NI. | NI | |||
| Dimethyl sulfoxide | NI | NI. | NI | |||
| Concentration (µg/mL) | Inhibition Halo (mm) Bacteria Gram-Negative | |||||
| Burkholderia cenocepacia | Salmonella paratyphi | Klebsiella pneumoniae | ||||
| CE | P-ACGs | CE | P-ACGs | CE | P-ACGs | |
| 4000 | 11.00 ± 0.01 aY | 11.75 ± 0.50 aX | 8.00 ± 0.01 cY | 12.25 ± 0.50 cdX | 8.00 ± 0.01 abX | 8.00 ± 0.01 bX |
| 2000 | 11.25 ± 0.50 aX | 12.00 ± 0.82 aX | 8.00 ± 0.01 cY | 11.50 ± 0.58 dX | 8.00 ± 0.01 abX | 9.00 ± 1.15 abX |
| 1000 | 10.75 ± 0.50 aX | 11.25 ± 0.50 aX | 8.00 ± 0.01 cY | 9.00 ± 0.01 eX | 8.00 ± 0.01 abX | 8.00 ± 0.01 bX |
| 800 | 11.50 ± 0.58 aX | 12.00 ± 0.82 aX | 12.00 ± 0.82 bY | 15.00 ± 0.01 aX | 8.50 ± 0.58 aY | 11.00 ± 0.82 aX |
| 400 | 11.50 ± 0.58 aX | 11.50 ± 0.58 aX | 12.25 ± 0.01 bY | 14.50 ± 0.58 abX | 7.75 ± 0.29 bY | 9.50 ± 1.29 abX |
| 200 | 10.50 ± 0.58 aX | 11.00 ± 0.01 aX | 12.00 ± 0.01 bY | 14.50 ± 1.29 abX | 7.75 ± 0.29 bX | 9.50 ± 1.73 abX |
| 100 | 11.00 ± 0.01 aX | 11.00 ± 0.82 aX | 11.50 ± 0.08 bY | 12.50 ± 0.58 cdX | 7.50 ± 0.01 bcY | 8.25 ± 0.50 bX |
| 50 | 10.75 ± 0.50 aX | 11.00 ± 0.01 aX | 14.00 ± 0.01 aX | 12.75 ± 0.50 cdY | 7.50 ± 0.01 bcY | 8.00 ± 0.01 bX |
| 25 | 10.00 ± 0.01 aY | 11.00 ± 0.01 aX | 12.50 ± 1.29 bX | 13.25 ± 0.50 bcX | 7.50 ± 0.01 bcY | 8.00 ± 0.01 bX |
| 12.5 | 10.00 ± 0.01 aY | 11.00 ± 0.01 aX | 12.50 ± 1.29 bX | 12.50 ± 0.58 cdX | 7.50 ± 0.01 bcY | 8.00 ± 0.01 bX |
| Ampicillin (500 μg/mL) | NI | 22.50 ± 0.50 * | N.I. | |||
| Distilled water | NI | NI | NI | |||
| Dimethyl sulfoxide | NI | NI | NI | |||
| Bacterial Strain | Crude Extract | Purified ACGs |
|---|---|---|
| MIC (µg/mL) | MIC (µg/mL) | |
| Streptococcus mitis | 12.50 | 0.36 |
| Listeria monocytogenes | 0.51 | 0.49 |
| Staphylococcus aureus | 1000 | 800 |
| Enterococcus faecalis | 0.78 | 0.67 |
| Streptococcus mutans | NI | 0.87 |
| Streptococcus salivaris | 12.5 | 12.5 |
| Burkholderia cenocepacia | 0.02 | 0.01 |
| Salmonella paratyphi | 0.67 | 0.12 |
| Klebsiella pneumoniae | 1.62 | 1.30 |
| Aeromonas hydrophila | 12.5 | 12.5 |
| Escherichia coli | 0.24 | 0.009 |
| Salmonella cholerasius | 0.51 | 0.09 |
| Bacteria | Lethality (Log CFU/mL) | |
|---|---|---|
| Crude Extract | Purified Acetogenins | |
| Enterococcus faecalis | 1.07 ± 0.06 aY | 1.27 ± 0.10 cX |
| Listeria monocytogenes | 0.96 ± 0.01 bY | 1.81 ± 0.08 aX |
| Escherichia coli | 0.35 ± 0.02 dX | 0.38 ± 0.03 dX |
Disclaimer/Publisher’s Note: The statements, opinions and data contained in all publications are solely those of the individual author(s) and contributor(s) and not of MDPI and/or the editor(s). MDPI and/or the editor(s) disclaim responsibility for any injury to people or property resulting from any ideas, methods, instructions or products referred to in the content. |
© 2022 by the authors. Licensee MDPI, Basel, Switzerland. This article is an open access article distributed under the terms and conditions of the Creative Commons Attribution (CC BY) license (https://creativecommons.org/licenses/by/4.0/).
Share and Cite
Aguilar-Hernández, G.; López-Romero, B.A.; Pérez-Larios, A.; Ruvalcaba-Gómez, J.M.; Castellanos-Huerta, I.; Tellez-Isaias, G.; Petrone-García, V.M.; Anaya-Esparza, L.M.; Montalvo-González, E. Antibacterial Activity of Crude Extract and Purified Acetogenins from Annona muricata Seeds. Appl. Sci. 2023, 13, 558. https://doi.org/10.3390/app13010558
Aguilar-Hernández G, López-Romero BA, Pérez-Larios A, Ruvalcaba-Gómez JM, Castellanos-Huerta I, Tellez-Isaias G, Petrone-García VM, Anaya-Esparza LM, Montalvo-González E. Antibacterial Activity of Crude Extract and Purified Acetogenins from Annona muricata Seeds. Applied Sciences. 2023; 13(1):558. https://doi.org/10.3390/app13010558
Chicago/Turabian StyleAguilar-Hernández, Gabriela, Brandon A. López-Romero, Alejandro Pérez-Larios, José M. Ruvalcaba-Gómez, Inkar Castellanos-Huerta, Guillermo Tellez-Isaias, Victor M. Petrone-García, Luis M. Anaya-Esparza, and Efigenia Montalvo-González. 2023. "Antibacterial Activity of Crude Extract and Purified Acetogenins from Annona muricata Seeds" Applied Sciences 13, no. 1: 558. https://doi.org/10.3390/app13010558
APA StyleAguilar-Hernández, G., López-Romero, B. A., Pérez-Larios, A., Ruvalcaba-Gómez, J. M., Castellanos-Huerta, I., Tellez-Isaias, G., Petrone-García, V. M., Anaya-Esparza, L. M., & Montalvo-González, E. (2023). Antibacterial Activity of Crude Extract and Purified Acetogenins from Annona muricata Seeds. Applied Sciences, 13(1), 558. https://doi.org/10.3390/app13010558

